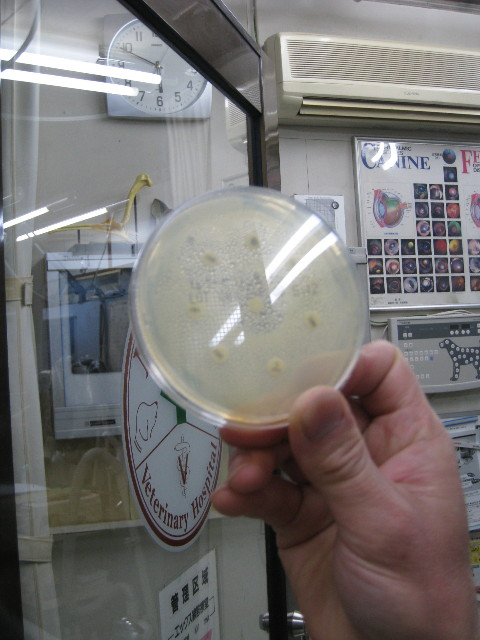
ファイル 655-3.jpg

昨夜ベベはあまりよく眠れなかったと思う。
熱は高くないのに立ったままおなかで息をしたり、立ったままうなだれたり、トイレに入っては何もしないで出てきたり、寝ようとしてベッドを掘るけど結局寝なかったり、やっと寝てもハアハアしたり。
お水もまたよく飲むようになった。
たぶんおなかが張って痛いのだろうね。。。。可哀相に。
ガーゼ交換は少なくても6時間おきくらいにはしてあげないと、何枚も滅菌ガーゼを重ねても漿液と膿でグショグショになる。
湿ってしまったネット腹巻きや、お洋服やベッドカバーは念のためアミアンピュアや獣医さんのAP水で消毒してからお洗濯。そして乾燥機にかける。
(たぶん)嫌気性の菌とはいえ、膿は清潔なものじゃないから....ベベやもいの為にね。
ガーゼ交換をしてもらうと、少しは気分が良いのかもいちゃんと一瞬だけ遊んだ。
●食欲があるのが救いだけど.....炎症を発見して治療をはじめてもう2週間になるのに、治癒の見込みはたっていない。
今の状態では腹膜炎になってしまい危険が高いのでとてもじゃないけど一か八かの手術に踏み切る事なんてできない。(先生も勧めない)
もしも....と思うと心配で心配で、でも手だてもないままの毎日は苦しい(..)
-本日の治療-
お熱はお耳も直腸も38.5度。ゴールデンのシニアの平熱ね。
●今日は患部のまわりが毛で不潔にならないよう、少し伸びてきた毛をまた毛刈りしてもらった。
●おへそのまわりのケツゴウシキは、手のひらほどの大きさになってしまいカチカチ。
(もしも手術するとしてもこんなに大きなものを全て手術でとるなんてとても無理だと思う。縫合できないと思う)
うんちをする時、結合織と貼っているガーゼが邪魔するのか?背中を(おなかを)思うように曲げる事が出来ずに中腰でうんちをするの。
ベベは痛くても苦しくても、治療も文句ひとついわずに頑張ってくれている。
なんとか早く治してあげたいよ!
●ベベのこの炎症は「脂肪織炎」の可能性もあるので、そうすると抗生剤ではなくステロイド治療が有効となるらしい。(そうだとすると腹膜炎にもならないので手術も可能?)
ベベは前にうちに帰ってきた頃「リウマチ因子」がプラスだったことがある。
(治療をしなくても次に調べたら治っていた。)
なので、また血液の免疫検査をすることにして血液を採取した。
●嫌気培養の結果がやっとでたが、結果はマイナスで失敗。(菌がはえなかった)
(明日、再再度嫌気培養に出す予定)
●今日は再度、好気培養を試みる為膿を採取した。
写真はよその子の好気培養。
(見にくいけど)昨日採取したものがすぐに菌が生えて、どの抗生剤が有効かもわかった。
ベベちゃんのも、好気培養か嫌気培養かどちらか成功しますように!
●ゆうべからあまり調子が良くないので、今日は熱があってもなくても消炎剤を飲ませてあげることになった。
すっかり暗い話題になってしまいました....。すみません(^^ゞ
このところベベのお散歩を控えていたので(乾いた路面を10分弱、日に2回程度歩くだけ)、今日久しぶりに駒沢公園に行ってみてびっくりしちゃった。
道路に面したところと、野球場のまわりの木がたくさん伐採されていた。
ほんのちょっとしか歩かなかったので全体はわからないけど、10mくらいの間で6本くらい伐採されていたから、100本はゆうにこえていると思う。
道路に面したところの一部には、新しく細くて背の高い木が植栽されていた。
おまけ写真
きゃっちゃんが闘病中のお休み時間によく行ってお世話になった、ながいき動物病院の近所のガソリンスタンドにベベともいと一緒に行ったよ。
きゃっちゃんはね、毎日の半日入院していて、1日7時間くらい点滴しないとならなかったんだけど、途中で1回お散歩に出るの。
そうするとグイグイとここに入っていって、おばちゃまにいつも可愛がってもらってたんだよo(*^-^*)o